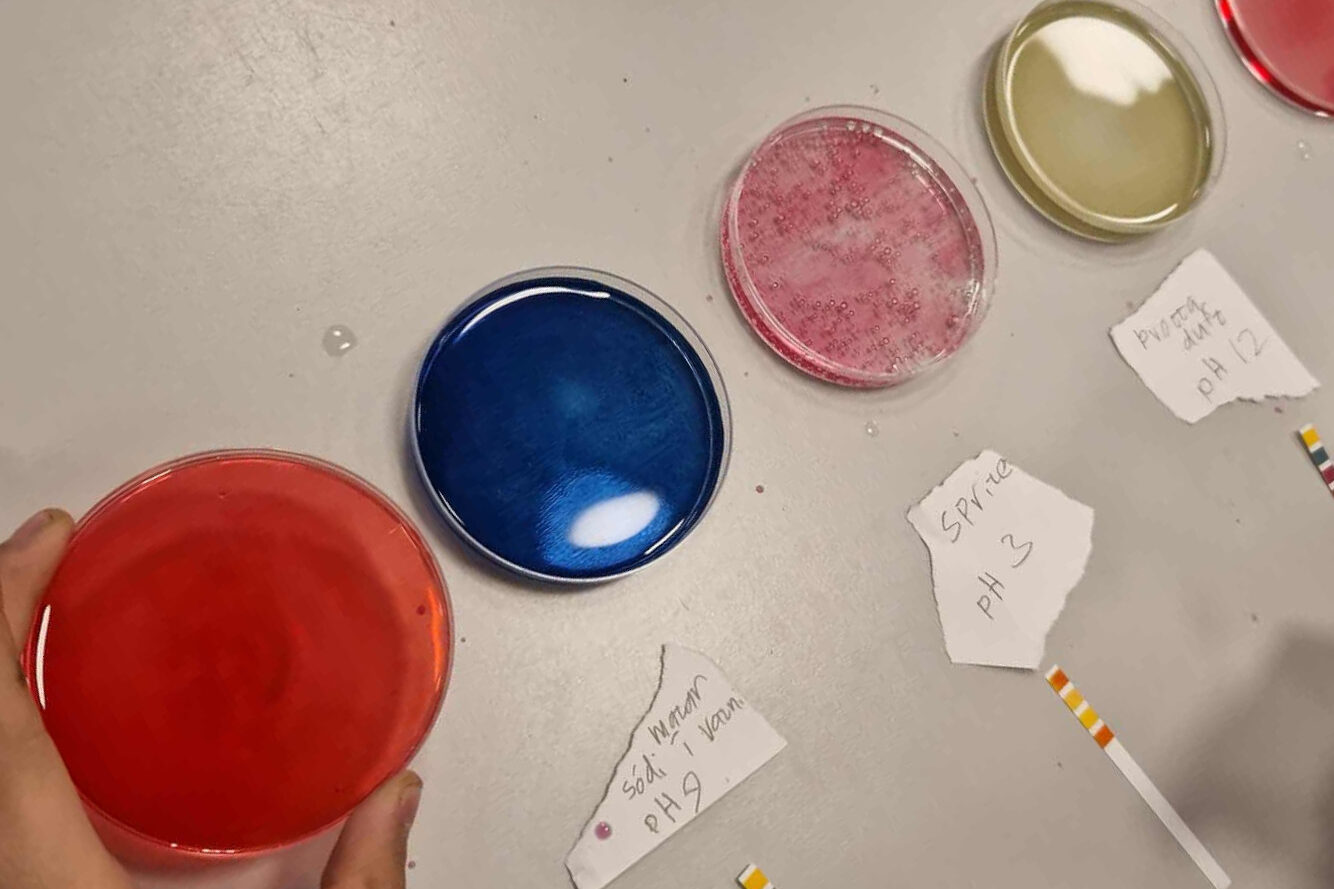

Hér má finna yfirlit yfir þær 15 vinnustofur sem í boði verða á LÆRT 2025. Til að tryggja að ekki flæði yfir um á sumar smiðjurnar verður þátttakendum dreift á smiðjurnar. Reynt verður að koma til móts við óskir þeirra í hvívetna en á móti kemur að smiðjurnar eru hver annarri betri og oft búa töfrarnir í hinu óvænta.
Vinnustofulota 1 – Föstudagur kl. 9:20-10:20
Leynilist með tungumáli tölvanna (Edda Björnsdóttir)
Hvernig getum við tengt saman tölvutækni, útiveru og listir?
Á vinnustofunni læra þátttakendur um tvíundakerfið (Binary code) og gagnaveituna (Fiber optic network) og nota hluti í náttúrunni til að gera listaverk með leyndum skilaboðum. Velt verður upp spurningum um hvernig má nýta stafróf/táknkerfi/mynstur í kennslu ólíkra viðfangsefna.

Mannslíkamaverkefni til að virkja nemendur (Þorbjörg Ólafsdóttir)
Kynnt verða verkefnahefti sem eru sett saman úr verkefnum úr 4. og 5. kafla sem fylgja bókinni Mannslíkaminn. Kaflarnir eru um húðina og stoð-, hreyfi- og taugakerfið. Skoðað er hvernig hægt er að blanda saman einföldum athugunum og lesskilningsverkefnum til að brjóta upp kennsluna og virkja nemendur í tengslum við námsefnið.

Sögur sem kveikja neista og gera ósýnilegt sýnilegt (Margrét Hugadóttir)
Hvernig getum við gert flókin viðfangsefni aðgengileg, eftirminnileg og skemmtileg? Á vinnustofunni kynnast þátttakendur krafti frásagnarinnar (storytelling)* í kennslu STEAM greina. Farið verður yfir hvernig saga getur kveikt forvitni og skilning og spreyta þátttakendur sig á sögugerð fyrir afmörkuð viðfangsefni í eigin kennslu. Notast verður við dæmi úr námsefninu Ósýnilegt verður sýnilegt þar sem fræðsla um ef til vill óspennandi innviði verður að ævintýrum.
* Athugið að ekki er um hina hefðbundnu söguaðferð að ræða.

Töfrar stærðfræðinnar (Guðbjörg Helga Guðmundsdóttir)
Í þessari dularfullu vinnustofu verða sýnd töfrabrögð, ykkur verður breytt í frosk og hugsanir ykkar lesnar (tvennt satt og ein lygi). Stærðfræðin er eins og allir vita dularfull og kyngimögnuð. Skoðum hvernig stærðfræðin getur blekkt og valdið undrun. Galdurinn býr í stærðfræðinni!

Vísindasmiðja í Ísaksskóla (Sigríður Hrund)
Í vinnustofunni verður farið yfir efnistök Vísindasmiðju Ísaksskóla sem haldin var samfleytt i 8 ár. Starf Vísindasmiðjunnar byggist á hugmyndafræði STEAM þar sem grunnþekkingu vísinda og lista er samþætt í skapandi leik og tilraunir. Efnistök fela m.a. í sér innlegg á lotukerfinu, rafsegulrófinu, mælingar, endurvinnslu, nýsköpun og frumkvöðlafræði.
Einkunnarorð Smiðjunnar eru öryggi, forvitni og gleði.

Vinnustofulota 2 – Föstudagur kl. 14:20-15:20
Hvað varð um fætur hvalsins? (Edda Elísabet Magnúsdóttir)
Í vinnusmiðjunni skoðum við hvernig hægt er að nýta núverandi þekkingu um þróun hvala til að varpa ljósi á stærri spurningar um þróun lífs á jörðinni og vistfræðilegt samhengi lífvera. Þátttakendur vinnusmiðjunnar prófa sjálfir ýmis verkefni og þrautir sem tengjast verkefninu “Hvað varð um fætur hvalsins?”. Einnig pælum við í því hvernig slíkt efni getur stutt við gagnrýna hugsun, samræður og röksemdafærslu og dýpri skilning á því hvernig vísindaleg þekking verður til og þróast.
Í vinnusmiðjunni verður farið yfir kennslufræðilega nálgun verkefnisins, tækifæri sem það skapar til að efla vísindalæsi og hvernig það styður við hæfniviðmið aðalnámskrár grunnskóla.

Lykilhæfni með LEGO (Hildur Sigfúsdóttir)
Í þessari vinnusmiðju fá þátttakendur tækifæri til að kynnast LEGO sem áhrifaríkri kennsluaðferð til að þjálfa og styrkja lykilhæfni í samskiptum og samvinnu. Með því að vinna saman að skapandi verkefnum með LEGO kubbum læra þátttakendur mikilvægi virkrar hlustunar, hvernig gefa þarf skýr og skiljanleg fyrirmæli og hvernig samvinna getur leitt til betri lausna.
Markmið vinnusmiðjunnar eru meðal annars að:
- Hvetja til skapandi hugsunar og lausnaleitar í hópum.
- Auka meðvitund um mikilvægi virkrar hlustunar í hópstarfi.
- Þjálfa þátttakendur í að gefa skýr og nákvæm fyrirmæli.
- Efla samvinnu og lausnamiðuð samskipti.

Stærðfræðispil (Þorsteinn G. Berghreinsson)
Kynnt verða nokkur spil sem nýtast vel í stærðfræði fyrir grunnskólanema. Þau gera námið myndrænt og mjög lifandi með skemmtilegan leik. Eitt spilanna þjálfar börn í að greina sundur tugi og einingar og eflir almennt hugarreikning á meðan annað skoðar þætti talna á afskaplega áhugaverðan og eftirminnilegan hátt. Fleiri spil og leikir koma við sögu þar sem einföld reiknifærni er í fyrirrúmi.

Uppgötvanir í Urriðaholti (Sigrún Edda Halldórsdóttir)
Í þessari vinnusmiðju verða framkvæmdar tvær verklegar æfingar sem henta til kennslu í náttúrufræði á mið- og unglingastigi. Önnur æfingin snýst um að taka bakteríusýni og færa yfir á agar í petrískál. Farið verður yfir hvað þarf að hafa í huga og hvaða efni og áhöld þarf fyrir sýnatökuna. Hin æfingin er að læra að nota rauðkálssafa sem litvísi í sýrustigsmælingum. Farið verður yfir hvernig eigi að undirbúa fyrir þessa tilraun og muninn á því að nota rauðkálssafa og rauðrófusafa.
Veðurmælingar (Brynja Stefánsdóttir)
Í þessari vinnustofu verður farið yfir það hvernig hægt er að smíða einfalda veðurmælistöð úr endurnýtanlegum efnum. Verkefnið tengir þannig saman náttúruvísindi, tækni, hönnun og stærðfræði í einu verkefni sem auðvelt er að framkvæma með nemendum. Við búum til regnmæli, vindmæli og hitamæli (frumstæða og einfalda) með það að markmiði að efla sýn og þekkingu á veðri. Við prófum þá saman og ræðum hvernig slík verkefni geti kveikt forvitni og sköpun hjá nemendum.
Markmið eru meðal annars:
- Að tengja veður og veðurmælingar við daglegt líf
- Að skilja ferli veðurmælinga
- Að nýta sköpun og lausnaleit við uppsetningu á veðurmælistöðvum

Vinnustofulota 3 – Laugardagur kl. 9:30-10:30
Garðfuglaverkefnið og Fjörulíf (Ólafur Einarsson)
Kynnt verða garðfuglaverkefnið sem hefur verið í gangi síðan 1994 og bjargir fyrir fjöruskoðun sem komið hefur verið fyrir á vefnum Fjörulíf.

Hagnýt ráð til að styðja við skilning á námsefni þvert á tungumál (Sigrún Þóra Skúladóttir)
Hvernig getum við stutt við bóklegt nám í náttúrufræði sem tekur mið af þörfum nemenda með annað tungumál en íslensku? Í þessari vinnusmiðju eru kynntar einfaldar og árangursríkar aðferðir sem hjálpa nemendum að skilja, ræða og vinna með námsefni í náttúrufræði þvert á tungumál. Þátttakendur fá að kynnast leiðum til að:
- nýta aðgengilegt lestrarumhverfi og brjóta námsefni niður í viðráðanlega hluta,
- nýta gervigreind til að útbúa samtöl og aðlaga námsefni.
- virkja alla nemendur með leiðsagnaraðferðum eins og tússtöflum, íspinnum og samtalsæfingum,
- útbúa skriftaræfingar beint úr námsefni,
- nota lestraraðferðir, hugarkort og Frayer-líkanið til að efla orðaforða og dýpka skilning,
Aðferðirnar byggja meðal annars á algildri hönnun náms (UDL) og leiðsagnarnámi og nýtast öllum nemendum í bekknum, óháð tungumáli eða bakgrunni. Markmiðið er að gera bóklega kennslu í náttúrufræði aðgengilega og virkja nemendur til þátttöku og umræðu.

Hugsandi skólastofa (Eyþór Eiríksson)
Hugsandi skólastofa er kennslunálgun í stærðfræði sem snýst um að skapa rými þar sem hugsun er í fyrirrúmi. Í vinnustofunni fara þátttakendur í spor nemenda og fá að upplifa á eigin skinni kennslustund í anda hugsandi skólastofu. Við munum skoða hvernig kennari getur tekið sín fyrstu skref í því að byggja upp hugsandi skólastofu en einnig nytsamlegar upplýsingar fyrir þau sem hafa nú þegar tekið fyrstu skref í að byggja upp hugsandi skólastofu.

Leikur að rafmagni (Martin Jónas B. Swift)
Farið verður í nokkrar einfaldar verklegar æfingar í rafmagnsfræði. Þátttakendur búa til voltahlöðu (einfalda rafhlöðu úr tveimur málmum, efnisbút og ediksýru) og pappírsrafrás. Farið verður yfir hvar útvega megi efni í vinnusmiðjuna, hvað beri að varast svo rafhlaðan og rafrásin virki örugglega, og boðið upp á samtal um fræðin sem liggja þarna að baki.
